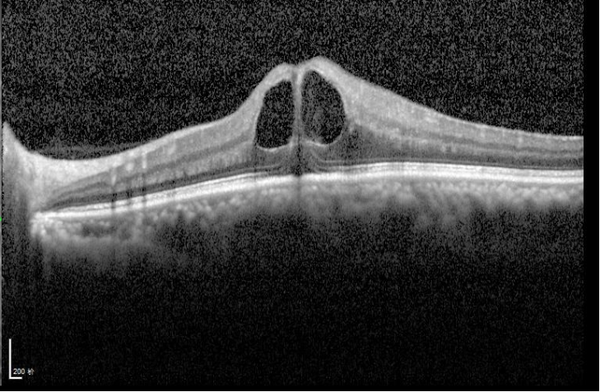
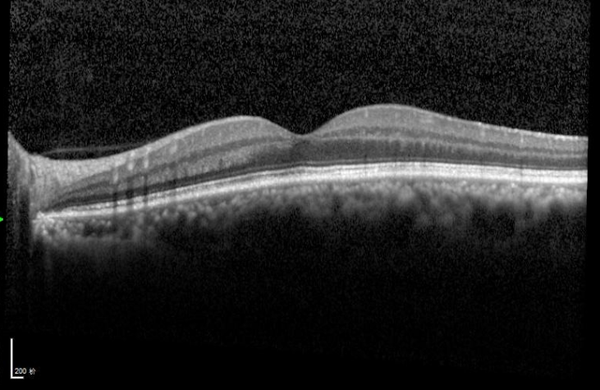

少花钱,省时间,“打”好眼底病攻坚战——“一站式”玻璃体腔注药为55岁教师再“注”光明!
时间:2025-10-28 14:51:08 来源:
过去的几个月,对于55岁的教师陈先生而言,仿佛是一场与时间赛跑的“视力保卫战”。
作为一名高血压患者,他万万没想到,眼底的血管危机竟会悄然侵袭视觉,让熟悉的讲台和板书变得一片模糊变形。
▶ 突发眼疾,视力降至0.1
前不久,高血压患者陈先生忽然感觉左眼视物模糊,由于工作繁忙,并未及时就医,当发现视力下降、视物变形,工作受到影响,才让其意识到问题严重性,陈先生立即前往河南大学附属爱尔眼科医院就诊。
而诊断结果显示陈先生左眼因高血压继发了视网膜颞上方分支静脉血管病变,而出血点已波及负责核心视力的黄斑区,并引发了严重的黄斑水肿,中心视力急剧下降至0.1。
▶ “一站式”眼内注药攻克黄斑水肿
“黄斑是我们的‘视力心脏’,一旦发生水肿,就如同相机的感光元件受潮,会直接导致中心视力模糊、扭曲,若不及时干预,可能造成不可逆的视功能损伤。”河南大学附属爱尔眼科医院眼底病科孙利娜主任解释道,“对于陈先生这种情况,当务之急是迅速消除黄斑水肿,挽救视细胞。”
在与陈先生充分沟通后,眼底病科团队为其制定了“一站式”门诊注药治疗方案——不需要住院即可将精准计量的抗VEGF药注入其左眼玻璃体腔内。不仅手术耗时短,而且费用低,几乎无痛的为陈先生的眼底病灶进行了一次“精准攻坚”。

短短十五天后复查,陈先生的左眼视力已从术前的0.1显著提升至0.4!通过OCT(光学相干断层扫描)等精密设备检查发现,其黄斑水肿已消退,视网膜结构层次变得清晰。
“我当时还以为要请假住院,比较费事,今天才知道现在可以不住院也能注药了,更方便、更省事了,不耽误工作......”陈先生对于“一站式”眼内注药中心给予了充分肯定。
眼内注药主要针对那些问题?
眼底病科孙利娜主任介绍:
“对于常见眼底疾病,如湿性老年性黄斑变性(wAMD)、糖尿病性黄斑水肿(DME)、视网膜静脉阻塞继发黄斑水肿(RVO-ME)及其他各类脉络膜新生血管(CNV)等,玻璃体腔注药以其操作安全性高,与其他给药途径相比具有起效更直接的优势,逐渐成为最主要的治疗手段。”


什么是“一站式”眼内注药?
据悉,传统的玻璃体腔注药治疗模式“预约难、流程繁、等待久”等问题一直是诊疗中的痛点,患者从确诊到注药需要多次来院、在院时间长、诊疗过程繁琐,对于部分患者治疗产生了一定不便。
孙主任表示:“一站式”眼内注药中心诊疗模式,大幅缩短患者的往返及等待时间,眼内注药由之前的需要住院2-3天缩短到2-3小时即可完成。

同时,“一站式”眼内注药中心通过诊疗流程、诊疗方案、眼健康守护“三合一”,为患者建立起从预防、保健、诊断,治疗、康复的全通路眼健康服务新模式。
未来,河南大学附属爱尔眼科医院将深化创新医疗服务水平,既要打好每次眼内注药的攻坚战,又要打好“一站式”玻璃体腔注药中心建设的持久战,竭力满足患者的眼健康需求。
